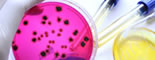
微生物（細菌検査）のイメージ画像

ご依頼方法
以下のファイルをダウンロード(Download)して、必要事項をご記入の上、メールもしくはFAXにてご依頼ください。後日、弊社よりご連絡差し上げます。 ご連絡にお時間を頂く場合もございますので、その点はご了承下さい。
★その他、どのようなことでもお気軽にお問い合わせください。 お問い合わせはこちら>>>
-
衛生管理アドバイス
支援 -
残留農薬分析・
残留抗生物質分析 -
カビ毒分析
-
重金属分析
-
理化学分析
-
特定原材料
(アレルギー物質) -
栄養成分分析
-
ビタミン分析
-
その他の成分分析
-
食品DNA検査
-
昆虫系異物検査
-
形態異物検査
-
機器異物検査
(EDS分析/IR分析) -
微生物(細菌検査)
・賞味期限検査 -
保菌・検便検査
-
ノロウィルス検査
-
放射能検査